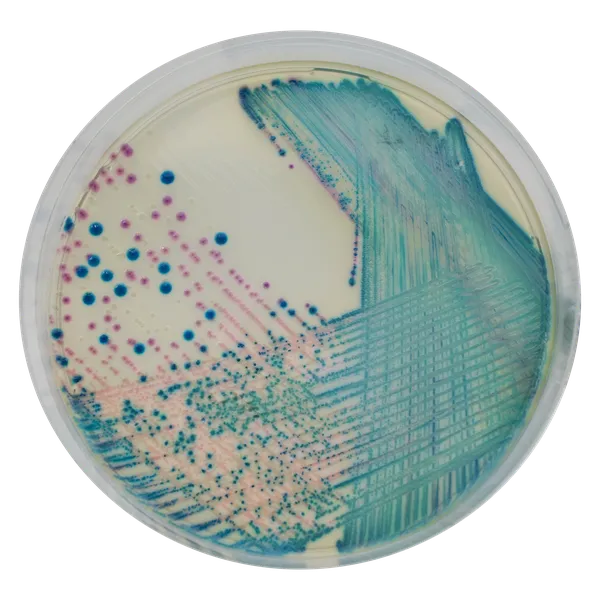
CHROMagar™ KPC

Colonies Appearance

E. coli CarbapenemR
dark pink to reddish

Klebsiella, Enterobacter, Citrobacter CarbapenemR
metallic blue (+/- red halo)

Pseudomonas CarbapenemR
translucent cream to blue

Acinetobacter CarbapenemR
cream, opaque
Performance
Performance
Worldwide reports of resistance to carbapenems found in Enterobacteriacae are a major health concern, specially in the case where the reducing susceptibility mechanism is the production of enzymes like KPC, OXA or MBL (ex: the recently reported NDM-1).
Carbapenems are the last resort in treating many serious gram-negative infections. However, production of these enzymes results in resistance to penicillins, cephalosporins (i.e., cefepime, ceftriaxone), carbapenems (i.e., meropenem, ertapenem), and aztreonam, thereby making these pathogens truly multidrug-resistant and making their treatment very challenging.
« KPC-producing bacteria have demonstrated a remarkable ability to disseminate with interfacility, interstate, and international transmission having been documented. » CDC 2008-R-24.
Thus, in order to limit the spread of these serious pathogens, rapid detection, followed by implementation of adequate infection control methods, is essential.
Application :
CHROMagar™ KPC is a selective and differential chromogenic culture medium, intended for use in the qualitative direct detection of gastrointestinal colonization with carbapenem-resistant Enterobacteria (CRE) to aid in the prevention and control of CRE in healthcare settings. The test is performed with rectal swab and stools from patients to screen for CRE colonization. Results can be interpreted after 18-24 h of aerobic incubation at 35-37 °C.
The medium can also be used as an early warning indicator for diagnostic tests of infections to signal the possible presence of multi drug-resistant bacteria. This use does not replace the institution’s protocols.
CHROMagar™ KPC is not intended to diagnose CRE infection nor to guide nor monitor treatment for infections. A lack of growth or the absence of colonies on CHROMagar™ KPC does not preclude the presence of CRE. Further identification, susceptibility testing, and epidemiological typing is needed on suspect colonies.
1. Detection after overnight incubation: Detection of Gram negative bacteria expressing a reduced susceptibility to antibiotics of the carbapenem family.
4. Flexibility: CHROMagar™ KPC supplement is supplied with a more than 18 months of shelf-life. This allows for flexibility of use whether in an epidemic situation with many patients to screen, or whether for random surveillance of cultures.
2. Time and workload savings: there is no need for a selective pre-enrichment medium. Direct plating of the sample is possible.

3. Short incubation: requires only 18-24 hours of incubation.
Composition

Technical Documents
Scientific Publications
2023
Evaluation of Five Phenotypic Methods of Carbapenemase Enzyme Detection, In Identification of Carbapenem resistant Pseudomonas aeruginosa.
📄 Publication2019
Assessment of the performance of CHROMagar KPC and Xpert Carba-R assay for the detection of carbapenem-resistant bacteria in rectal swabs: First comparative study from Abu Dhabi, United Arab Emirates
📄 Publication2017
Evaluation of meat, fruit and vegetables from retail stores in five United Kingdom regions as sources of extended-spectrum beta-lactamase (ESBL)-producing and carbapenem-resistant Escherichia coli.
📄 Publication2017
Molecular characterization of intestinal carriage of carbapenem-resistant Enterobacteriaceae among inpatients at two Iranian university hospitals: first report of co-production of blaNDM-7 and blaOXA-48
📄 Publication2017
Detection of carbapenemase-producing Enterobacteriaceae in rectal surveillance cultures in non-hospitalized patients
📄 Publication2017
Rapid detection of carbapenem-resistant isolates Enterobacteriaceae from the blood culture
📄 Publication2017
Carbapenemase-producing Gram-negative bacteria in the Russian research center of radiology and surgical technologies
📄 Publication2016
Identification of Klebsiella pneumoniae Carbapenemase-producing Klebsiella oxytoca in Clinical Isolates in Tehran Hospitals, Iran by Chromogenic Medium and Molecular Methods
📄 Publication2014
Clinical Microbiology costs of methods of active surveillance for Klebsiella pneumoniae Carbapenemase-producing Enterobacteriaceae
📄 Publication2014
Comparación de métodos para la detección de Klebsiella pneumoniae productora de Carbapenemasa (KPC) en muestras de hisopados rectales procesadas en el C.H.Dr.A.A.M
📄 Publication2014
Detection of carbapenemases in Enterobacteriaceae: a challenge for diagnostic microbiological laboratories
📄 Publication2014
Laboratory evaluation of different agar media for isolation of carbapenem-resistant Acinetobacter spp.
📄 Publication2013
A study on prevalence of KPC producing from Klebsiella pneumoniae using modified hodge test and CHROMagar in Iran
📄 Publication2013
Comparative evaluation of selective agar media, MALDI-TOF MS, PCR and phenotypic methods for the detection of Carbapenemase-producing Enterobacteriaceae
📄 Publication2013
Nosocomial Transmission of New Delhi Metallo-β-Lactamase-1-Producing Klebsiella pneumoniae in Toronto, Canada
📄 Publication2013
Gram-Negative Bacteria That Produce Carbapenemases Causing Death Attributed to Recent Foreign Hospitalization
📄 Publication2013
Evaluation of three selective chromogenic media, CHROMagar ESBL, CHROMagar CTX-M and CHROMagar KPC, for the detection of Klebsiella pneumoniae producing OXA-48 carbapenemase
📄 Publication2012
CHROMagar KPC. Comparación con el método propuesto por los Centros para el Control y Prevención de Enfermedades (CDC, EE.UU.) para el estudio de portación rectal y evaluación de falsos positivos
📄 Publication2012
Nosocomial outbreak of carbapenem resistant Enterobacter cloacae highlighting the interspecies transferability of the blaOXA-48 gene in the gut flora
📄 Publication2012
Comparison of Two Chromogenic Media and MacConkey Agar with Carbapenem Disks for the Detection of Carpabenemase-Producing Gram Negative Rods in Simulated Stool Specimens
📄 Publication2012
Persistence of NDM-1-producing enterobacteria over a 6-month period in a French community patient
📄 Publication2012
Nosocomial outbreak of carbapenem-resistant Enterobacter clocae highlighting the interspecies transferability of the blaOXA-48 gene in the gut flora
📄 Publication2011
Evaluation of CHROMagar KPC for the detection of carbapenemase-producing Enterobacteriaceae in rectal surveillance cultures
📄 Publication2011
A Novel Variant, NDM-5, of the New Delhi Metallo--Lactamase in a Multidrug-Resistant Escherichia coli ST648 Isolate Recovered from a Patient in the United Kingdom
📄 Publication2010
CHROMagar KPC evaluation for detection of carbapenemase producing Enterobacteriaceae
📄 Publication2009
Poster: Evaluation of CHROMagar KPC for Rapid Detection of Carbapenem-Resistant Enterobacteriaceae
📄 Publication2009
Evaluation of CHROMagar KPC and Other Selective Media for Surveillance of Carbapenemase-producing Enterobacteriaceae and Multi-drug resistant Acinetobacter species
📄 Publication2008
Evaluation of CHROMagar KPC for Rapid Detection of Carbapenem-Resistant Enterobacteriaceae
📄 Publication

Read more